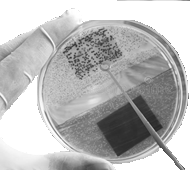
juego biológico

Mejoramiento I Término 2005 - 2006. Septiembre 13, 2005 /ICM00794
Tema 2. (30 puntos)
Para simular un juego biológico se almacena en una matriz nxn números aleatorios 0 o 1.
El 1 corresponde a un ser vivo.
a. Determine el porcentaje de seres vivos generados.
| 0 | 1 | 0 | 1 |
| 0 | 1 | 0 | 0 |
| 1 | 1 | 1 | 0 |
| 0 | 1 | 0 | 0 |
| 0 | 0 | 0 | 1 |
| 0 | 0 | 0 | 0 |
b. Para el primer ciclo de análisis, busque en la matriz si existen seres vivos rodeados en sus cuatro lados de otros seres vivos. En este caso, se considera superpoblación, por lo que se cambia el ser vivo de 1 a 0. Determine el nuevo porcentaje de seres vivos.
| 0 | 1 | 0 | 1 |
| 0 | 1 | 0 | 0 |
| 1 | 0 | 1 | 0 |
| 0 | 1 | 0 | 0 |
| 0 | 0 | 0 | 1 |
| 0 | 0 | 0 | 0 |
Rúbrica: Literal a (15 puntos), literal b (15 puntos)